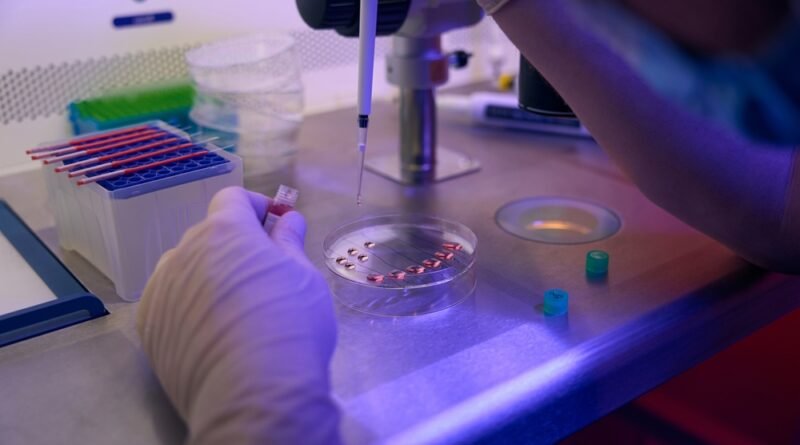

“Hipertiroidi Nedir? İşte İşinize Yarayan Etkili Tedavi Yöntemleri!”
Hipertiroidi, tiroid bezinin aşırı aktif hale gelmesi sonucu vücutta gereğinden fazla tiroid hormonu üretmesidir. Belirtileri arasında hızlı kalp atışı, kilo kaybı ve aşırı terleme bulunur.